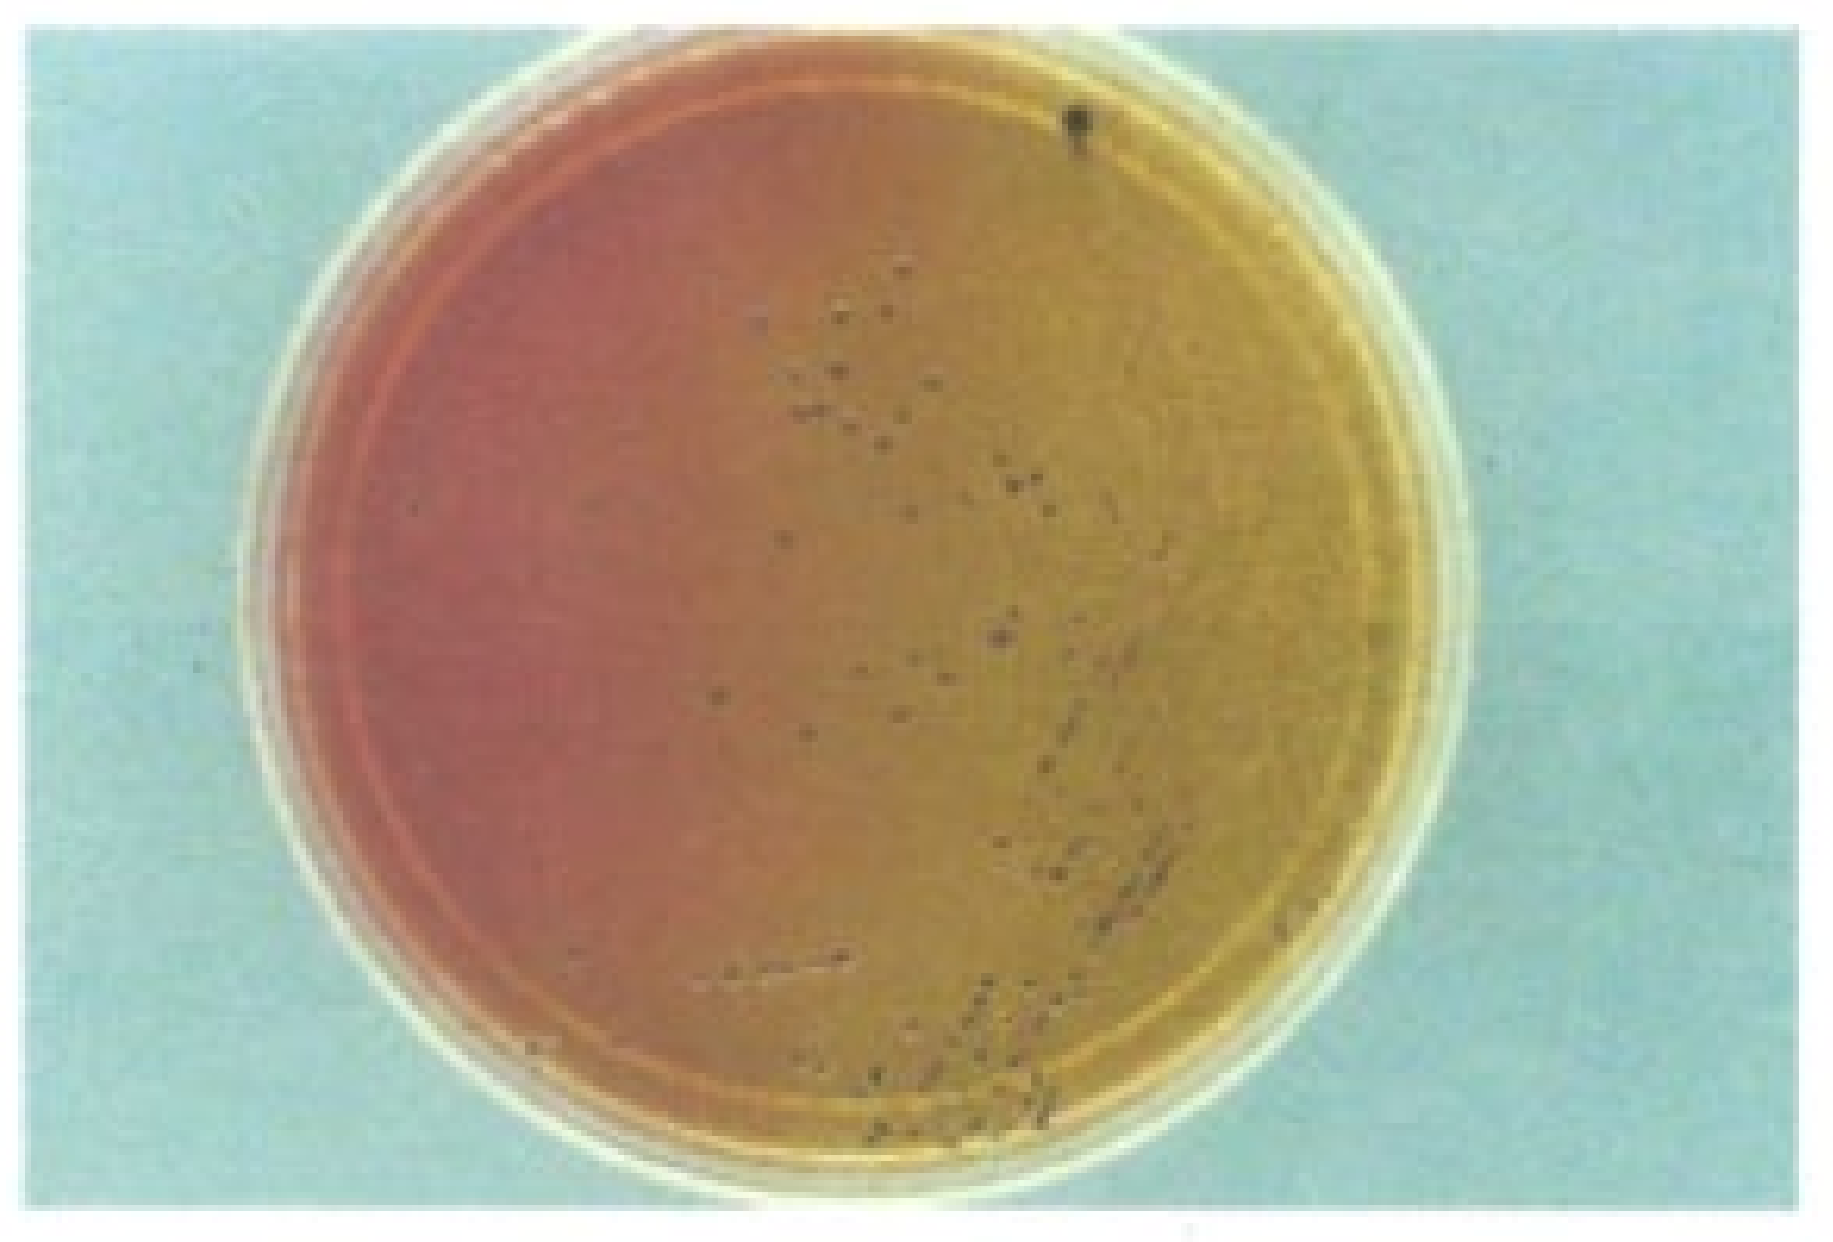
Microorganisms 12 01031 g002 Microorganisms 12 01031 g002

Expanding the Spectrum of Diseases and Disease Associations Caused by Edwardsiella tarda and Related Species
Abstract
1. Introduction
1.1. Historical Review
1.2. Current Perspective
2. Edwardsiella Taxonomy
2.1. Nomenclature and Species Assignment
2.2. Classification: Past to Present
2.3. Taxonomic Issues
3. Epidemiology
3.1. Environmental Distribution—Overview
3.2. Factors Regulating Environmental Distribution
3.3. Human Infections
3.3.1. Vehicles of Infection
Food Consumption
Animal-Associated Trauma
Aquatic and Occupational Exposures
3.3.2. Risk Factors
3.4. Zoonotic Infections and Distribution
3.4.1. Piscine Species
3.4.2. Vertebrate Species
3.4.3. Reptiles
3.4.4. Miscellaneous Groups (Birds, etc.)
4. Diagnostic Microbiology
4.1. Genus Characteristics
4.2. E. tarda
4.2.1. Culture
4.2.2. Biochemical Traits
Biogroup 1 and Related Strains
4.2.3. Molecular Identification
4.3. E. ictaluri
4.3.1. Culture
4.3.2. Biochemical Traits
4.3.3. Molecular Identification
4.4. E. piscicida
4.4.1. Culture
4.4.2. Biochemical Traits
4.4.3. Molecular Identification
5. Edwardsiella Infections in Humans and Animals
5.1. Human Infections
5.1.1. Gastrointestinal Syndromes
| Study | Country | Study Period | Population | Disease Presentation | E. tarda Prevalence (%) | Co-Pathogens Present a | |
|---|---|---|---|---|---|---|---|
| Patients | Controls | ||||||
| Bhat et al. [137] | India | 1963–1965 | Rural, Urban | Juvenile diarrhea | 0.48 | 0 | 25 (%) |
| Gilman et al. [138] | Malaysia | NG | Orang Asli | Bloody diarrhea | 13.9 | 0.8 | 86 (%) |
| Iveson et al. [106] | W. Australia | NG | Aboriginal | AGE | 0.3 | NG | 27.5% |
| Makulu et al. [139] | Zaire b | 1965–1972 | Zaïrese (88%) Europeans (12%) | AGE | 0.25 | 0 | 49% |
| Kourany et al. [93] | Panama | 1965–1972 | Urban, Rural | AGE | 0.33 | 0/0.66 c | 10% |
5.1.2. Septicemia
5.1.3. Wound Infections
5.1.4. CNS Illnesses
5.1.5. Miscellaneous Infections
5.2. Piscine and Animal Infections
5.2.1. Fish Diseases
5.2.2. Outbreaks
5.2.3. Vertebrates and Other Groups
6. Pathogenicity
6.1. Virulence Factors
6.2. Virulence Factors That Have Been Associated with Human Disease
6.3. Animal Studies or Models of Infection
7. Antimicrobial Susceptibility
7.1. E. tarda Susceptibility Profiles: Human Infections
7.2. Edwardsiella Susceptibility Profiles: Piscine Species
8. Prevention and Control
8.1. Breaking the Chain
8.2. Vaccine Development
| Fish Species | Vaccine Type/Strain | Administration Route | Region | Relative Percentage Survival (RPS) | Targeted Edwardsiella Species |
|---|---|---|---|---|---|
| Olive Flounder | Various recombinant and live attenuated vaccines | Intraperitoneal, immersion | China, South Korea, Japan | 45–100% | E. tarda |
| Turbot | Recombinant attenuated and others | Immersion, intraperitoneal | China | 35.7–83% | E. tarda |
| Zebrafish | Recombinant flagellar protein FlgD | Not specified | China | 70% | E. tarda |
| Flounder | Recombinant, subunit, DNA vaccines | Intraperitoneal, oral, immersion | China | 60–88.9% | E. tarda |
| Rohu | Attenuated E. tarda strain | Immersion | India | 80% | E. tarda |
| European Eel | Recombinant protein vaccines | Intraperitoneal | Spain | 75–85% | E. tarda |
| Large Yellow Croaker | Live attenuated vaccine | Oral | China | 85.7% | E. tarda |
| Channel Catfish | Inactivated vaccine | Immersion | China | 62% | E. tarda |
| Japanese Flounder | DNA vaccine | Injection | China | 85% | E. tarda |
| Catfish | Inactivated E. ictaluri (outer membrane proteins) | Intraperitoneal (IP) | - | - | E. ictaluri * |
9. Conclusions
Author Contributions
Funding
Data Availability Statement
Conflicts of Interest
References
- Abbott, S.L.; Janda, J.M. The Genus Edwardsiella. In Prokaryotes, 3rd ed.; Dworkin, M., Falkow, S., Rosenberg, E., Schleifer, K.-H., Stackebrandt, E., Eds.; Springer: New York, NY, USA, 2006; Volume 6, pp. 72–89. [Google Scholar]
- Sakazaki, R. Studies on the Asakusa group of Enterobacteriaceae (Edwardsiella tarda). Jpn. J. Med. Sci. Biol. 1967, 20, 205–212. [Google Scholar] [CrossRef]
- King, B.M.; Adler, D.L. A previously undescribed group of Enterobacteriaceae. Am. J. Clin. Pathol. 1964, 41, 230–232. [Google Scholar] [CrossRef]
- Farmer, J.J., III. The Genus Edwardsiella. In The Prokaryotes; Starr, M.P., Stolp, H., Trüper, H.G., Balows, A., Schlegel, H.G., Eds.; Springer: New York, NY, USA, 1981; pp. 1135–1139. [Google Scholar]
- Ewing, W.H.; McWhorter, A.C.; Escobar, M.R.; Lubin, A.H. Edwardsiella, a new genus of Enterobacteriaceae based on a new species, E. tarda. Int. Bull. Bacteriol. Nomen. Taxon. 1965, 15, 33–38. [Google Scholar] [CrossRef]
- Henry, R. Etymologia: Edwardsiella tarda. Emerg. Infect. Dis. 2019, 25, 1833. [Google Scholar] [CrossRef]
- Gonzales, A.B.; Ruffolo, E.H. Edwardsiella tarda: Etiologic agent in a post-traumatic subgleal abscess. South. Med. J. 1966, 59, 340. [Google Scholar] [CrossRef] [PubMed]
- Sonnenwirth, A.C.; Kallus, B.A. Meningitis due to Edwardsiella tarda. Am. J. Clin. Pathol. 1968, 49, 92–95. [Google Scholar] [CrossRef]
- Okubadejo, O.A.; Alausa, K.O. Neonatal meningitis caused by Edwardsiella tarda. Br. Med. J. 1968, 3, 357–358. [Google Scholar] [CrossRef]
- Ewing, W.H. Edwardsiella. In Identification of Enterobacteriaceae, 4th ed.; Elsevier: New York, NY, USA, 1986; pp. 173–179. [Google Scholar]
- Bockemühl, J.; Pan-Urai, R.; Burkhardt, F. Edwardsiella tarda associated with human disease. Path. Microbiol. 1971, 37, 393–401. [Google Scholar] [CrossRef]
- PubMed®; NIH National Library of Medicine. Online Edwardsiella—Search Results—PubMed (nih.gov). Online Resource, Public Database. Available online: https://pubmed.ncbi.nlm.nih.gov (accessed on 10 February 2024).
- Wilson, J.P.; Waterer, R.E.; Wofford, J.D., Jr.; Chapman, S.W. Serious infections with Edwardsiella tarda. A case report and review of the literature. Arch. Intern. Med. 1989, 149, 208–210. [Google Scholar] [CrossRef]
- Janda, J.M.; Abbott, S.L. Infections associated with the genus Edwardsiella: The role of Edwardsiella tarda in human disease. Clin. Infect. Dis. 1993, 17, 742–748. [Google Scholar]
- Machimbirke, V.I.; Crumlish, M.; Dong, H.T.; Santander, J.; Khunrae, P.; Rattanarojpong, T. Edwardsiella ictaluri: A systemic review and future perspectives on disease management. Rev. Aquac. 2022, 14, 1613–1636. [Google Scholar] [CrossRef]
- Leung, K.Y.; Wang, Q.; Yang, Z.; Siame, B.A. Edwardsiella piscicida: A versatile emerging pathogen of fish. Virulence 2019, 10, 555–567. [Google Scholar] [CrossRef] [PubMed]
- Brenner, D.J.; Fanning, G.R.; Steigerwalt, A.G. Polynucleotide sequence relatedness in Edwardsiella tarda. Int. J. Syst. Bacteriol. 1974, 24, 186–190. [Google Scholar] [CrossRef][Green Version]
- Skerman, V.B.D.; McGowan, V.; Sneath, P.H.A. Approved lists of bacterial names. Int. J. Syst. Bacteriol. 1980, 30, 225–420. [Google Scholar] [CrossRef]
- Grimont, P.A.D.; Grimont, F.; Richard, C.; Sakazaki, R. Edwardsiella hoshinae, a new species of Enterobacteriaceae. Curr. Microbiol. 1980, 4, 347–351. [Google Scholar] [CrossRef]
- Hawke, J.P.; McWhorter, A.C.; Steigerwalt, A.G.; Brenner, D.J. Edwardsiella ictaluri sp. nov., the causative agent of enteric septicemia of catfish. Int. J. Syst. Bacteriol. 1981, 31, 396–400. [Google Scholar] [CrossRef]
- Abayneh, T.; Colquhoun, D.J.; Sørum, H. Edwardsiella piscicida sp. nov., a novel species pathogenic for fish. J. Appl. Microbiol. 2012, 114, 644–654. [Google Scholar] [CrossRef] [PubMed]
- Shao, S.; Lai, Q.; Liu, Q.; Wu, H.; Xiao, J.; Shao, Z.; Wang, Q.; Zhang, Y. Phylogenomics characterization of a highly virulent Edwardsiella strain ET080813T encoding two distinct T3SS and three T6SS gene clusters: Propose a novel species as Edwardsiella anguillarum sp. nov. Syst. Appl. Microbiol. 2015, 38, 36–47. [Google Scholar] [CrossRef] [PubMed]
- Buján, N.; Mohammed, H.; Balboa, S.; Romalder, J.L.; Toranzo, A.E.; Arías, C.R.; Magariños, B. Genetic studies to re-affiliate Edwardsiella tarda fish isolates to Edwardsiella piscicida and Edwardsiella anguillarum species. Syst. Appl. Microbiol. 2018, 41, 30–37. [Google Scholar] [CrossRef]
- LPSN—List of Prokaryotic Names with Standing in Nomenclature. Available online: http://bacterio.net (accessed on 10 February 2024).
- Ewing, W.H. Deoxyribonucleic acid (DNA) hybridization. In Identification of Enterobacteriaceae, 4th ed.; Elsevier: New York, NY, USA, 1986; pp. 17–25. [Google Scholar]
- Alnajar, S.; Gupta, R.S. Phylogenomics and comparative genomic studies delineate six main clades within the family Enterobacteriaceae and support reclassification of several polyphyletic members of the family. Infect. Genet. Evol. 2017, 54, 108–127. [Google Scholar] [CrossRef]
- Adeolu, M.; Alnajar, S.; Naushad, S.; Gupta, R.S. Genome-based phylogeny and taxonomy of the ‘Enterobacteriales’: Proposal for Enterobacteriales ord. nov. divided into families Enterobacteriaceae, Erwiniaceae fam. nov., Pectobacteriaceae fam. nov., Yersiniaceae fam. nov., Hafniaceae fam. nov., Morganellaceae fam. nov., and Budviciaceae fam. nov. Int. J. Syst. Evol. Microbiol. 2016, 66, 5575–5599. [Google Scholar]
- Janda, J.M.; Abbott, S.L. The changing face of the family Enterobacteriaceae (Order: “Enterobacterales”): New members, taxonomic issues, geographic expansion, and new diseases and disease syndromes. Clin. Microbiol. Rev. 2021, 34, e00174-20. [Google Scholar] [CrossRef]
- Tindall, B.J. On the synonymy of Edwardsiella tarda Ewing and McWhorter 1965 (Approved Lists 1980) and Edwardsiella anguillimortifera (Hoshina 1962) Sakazaki and Tamura 1975 (Approved Lists 1980), an old problem in need of a solution. Int. J. Syst. Evol. Microbiol. 2016, 66, 4910–4912. [Google Scholar] [CrossRef] [PubMed]
- Buján, N.; Balboa, S.; Romalde, J.L.; Toranzo, A.E.; Magariños, B. Population genetic and evolution analysis of controversial genus Edwardsiella by multilocus sequence typing. Mol. Phylogenet. Evol. 2018, 127, 513–521. [Google Scholar] [CrossRef]
- Armwood, A.R.; Griffin, M.J.; Richardson, B.M.; Wise, D.J.; Ware, C.; Camus, A.C. Pathology and virulence of Edwardsiella tarda, Edwardsiella piscicida, and Edwardsiella anguillarum in channel (Ictalurus punctatus), blue (Ictalurus furcatus), and channel X blue hybrid catfish. J. Fish Dis. 2022, 45, 1683–1698. [Google Scholar] [CrossRef] [PubMed]
- Austin, B.; Austin, D.A. Enterobacteriaceae representatives. In Bacterial Fish Pathogens: Disease of Farmed and Wild Fish; Springer: New York, NY, USA, 2016; pp. 323–396. [Google Scholar]
- Leung, K.Y.; Wang, Q.; Zheng, X.; Zhuang, M.; Yang, Z.; Shao, S.; Achmon, Y.; Siame, B.A. Versatile lifestyles of Edwardsiella: Free-living, pathogen, and core bacterium of the aquatic resistome. Virulence 2022, 13, 5–18. [Google Scholar] [CrossRef]
- Joh, S.J.; Kim, M.J.; Kwon, H.M.; Ahn, E.H.; Jang, H.; Kwon, J.H. Characterization of Edwardsiella tarda isolated from farm-cultured eels, Anguilla japonica, in the Republic of Korea. J. Vet. Med. Sci. 2011, 73, 7–11. [Google Scholar] [CrossRef]
- Sakazaki, R. The new group of the Enterobacteriaceae. Jpn. J. Bacteriol. 1962, 17, 616–617. [Google Scholar]
- Cooney, S.; O’Brien, S.; Iversen, C.; Fanning, S. Bacteria: Other pathogenic Enterobacteriaceae–Enterobacter and other genera. In Encyclopedia of Food Safety; Motarjemi, Y., Ed.; Academic Press: Oxford, UK, 2014; Volume 1, pp. 431–433. [Google Scholar]
- Van Damme, L.R.; Vandepitte, J. Frequent isolation of Edwardsiella tarda and Pleisiomonas shigelloides from healthy Zairese freshwater fish: A possible source of sporadic diarrhea in the tropics. Appl. Environ. Microbiol. 1980, 39, 475–479. [Google Scholar] [CrossRef]
- Soto, E.; Illanes, O.; Revan, F.; Griffin, M.; Riofrio, A. Bacterial distribution and tissue targets following experimental Edwardsiella ictaluri infection in Nile tilapia Oreochromis niloticus. Dis. Aquat. Org. 2013, 104, 105–112. [Google Scholar] [CrossRef]
- Yamada, Y.; Wakabayashi, H. Identification of fish-pathogenic strains belonging to the genus Edwardsiella by sequence analysis of sodB. Fish Pathol. 1999, 34, 145–150. [Google Scholar] [CrossRef]
- Janda, J.M.; Abbott, S.L.; Kroske-Bystrom, S.; Cheung, W.K.; Powers, C.; Kokka, R.P.; Tamura, K. Pathogenic properties of Edwardsiella species. J. Clin. Microbiol. 1991, 29, 1997–2001. [Google Scholar] [CrossRef] [PubMed]
- Katharios, P.; Kalatzis, P.G.; Kokkari, C.; Pavlidis, M.; Wang, Q. Characterization of a highly virulent Edwardsiella anguillarum strain isolated from Greek aquaculture, and a spontaneously induced prophage therein. Front. Microbiol. 2019, 10, 141. [Google Scholar] [CrossRef] [PubMed]
- Akgul, A.; Akgul, A.; Lawrence, M.L.; Karsi, A. Stress-related genes promote Edwardsiella ictaluri pathogenesis. PLoS ONE 2018, 13, e0194669. [Google Scholar] [CrossRef] [PubMed]
- Yang, M.; Lv, Y.; Xiao, J.; Wu, H.; Zheng, H.; Liu, Q.; Zhang, Y.; Wang, Q. Edwardsiella comparative phylogenomics reveal the new intra/inter-species taxonomic relationships, virulence evolution and niche adaptation mechanisms. PLoS ONE 2012, 7, e36987. [Google Scholar] [CrossRef] [PubMed]
- Janda, J.M.; Abbott, S.L. The Genus Edwardsiella. In The Enterobacteria, 2nd ed.; ASM Press: Washington, DC, USA, 2006; pp. 301–319. [Google Scholar]
- Slaven, E.M.; Lopez, F.A.; Hart, S.M.; Sanders, C.V. Myonecrosis caused by Edwardsiella tarda: A case report and case series of extraintestinal E. tarda infections. Clin. Infect. Dis. 2001, 32, 1430–1433. [Google Scholar] [CrossRef] [PubMed]
- Hirai, Y.; Asahata-Tago, S.; Ainoda, Y.; Fujita, T.; Kikuchi, K. Edwardsiella tarda bacteremia. A rare but fatal water- and foodborne infection: Review of the literature and clinical cases from a single centre. Can. J. Infect. Dis. Med. Microbiol. 2015, 26, 313–318. [Google Scholar] [CrossRef] [PubMed]
- Hasegawa, K.; Kenya, M.; Suzuki, K.; Ogawa, Y. Characteristics and prognosis of patients with Edwardsiella tarda bacteremia at a single institution, Japan, 2005–2022. Ann. Clin. Microbiol. Antimicrob. 2022, 21, 56. [Google Scholar] [CrossRef] [PubMed]
- Healey, K.D.; Rifal, S.M.; Rifal, A.O.; Edmond, M.; Baker, D.S.; Rifal, K. Edwardsiella tarda: A classic presentation of a rare fatal infection, with possible new background risk factors. Am. J. Case Rep. 2021, 22, e934347. [Google Scholar] [CrossRef]
- Vandepitte, J.; Lemmens, P.; De Swert, L. Human edwardsiellosis traced to ornamental fish. J. Clin. Microbiol. 1983, 17, 165–167. [Google Scholar] [CrossRef]
- Manchanda, V.; Singh, N.P.; Eidels, H.K.; Shamweel, A.; Thukral, S.S. Liver abscess caused by Edwardsiella tarda biogroup 1 and identification of its epidemiological triad by ribotyping. Indian J. Med. Microbiol. 2006, 24, 135–137. [Google Scholar] [CrossRef]
- Chieochanthanakij, R.; Manuprasert, W.; Udomsantisuk, N.; Pearson, L.J.; Kanjanabuch, T. Genetically confirmed Edwardsiella tarda peritonitis was associated with improper caregiver’s hand hygiene during peritoneal dialysis bag exchange. Case Rep. Nephrol. Dial. 2022, 12, 11–15. [Google Scholar] [CrossRef] [PubMed]
- Tsuji, A.; Hirasawa, K.; Arakuma, T.; Izumi, K.; Kobori, K.; Sunohara, K.; Yoshizawa, N.; Watanabe, H.; Izumiya, I. A 12-year-old boy with acute gastroenteritis caused by Edwardsiella tarda O4:H4. J. Infect. Chemother. 2008, 14, 433–435. [Google Scholar] [CrossRef] [PubMed]
- Suzuki, K.; Yanai, M.; Hayashi, Y.; Otsuka, H.; Kato, K.; Soma, M. Edwardsiella tarda bacteremia with poas and epidural abscess as a food-borne infection: A case report and literature review. Intern. Med. 2018, 93, 14–17. [Google Scholar]
- Sarathi, S.; Brahma, A.; Das, P.K.; Mahapatra, A.; Behera, B. Edwardsiella tarda causing fishbone injury cellulitis leading to sepsis in a case of hematological malignancy—A rare report and review of the literature. J. Lab. Physicians 2023, 15, 602–607. [Google Scholar] [CrossRef] [PubMed]
- Nagel, P.; Serritella, A.; Layden, T.J. Edwardsiella tarda gastroenteritis associated with a pet turtle. Gastroenterology 1982, 82, 1436–1437. [Google Scholar] [CrossRef]
- Gilani, A.; Sarmadian, R.; Kahbazi, M.; Yousefichaijan, P. Urinary tract infection caused by Edwardsiella tarda: A report of the first case in Iran. BMC Infect. Dis. 2022, 22, 962. [Google Scholar] [CrossRef] [PubMed]
- Spencer, J.D.; Hastings, M.C.; English, B.K.; Ault, B.H. Gastroenteritis caused by Edwardsiella tarda in a pediatric renal transplant recipient. Pediatr. Transplant. 2007, 12, 238–241. [Google Scholar] [CrossRef]
- Tsuchiya, K.; Okano, I.; Miyamoto, Y.; Maroyama, H.; Komuro, Y.; Kudo, Y.; Toyone, T.; Inagaki, K. Thoracic spondylitis associated with sepsis and neurological deficit caused by Edwardsiella tarda: A case report. Spine Surg. Relat. Res. 2023, 7, 547–550. [Google Scholar] [CrossRef]
- Zambon, L.S.; Marta, G.N.; Chehter, N.; Del Nero, L.G.; Cavallaro, M.C. Near-drowning-associated pneumonia with bacteremia caused by coinfection with methicillin-susceptible Staphylococcus aureus and Edwardsiella tarda in a healthy white man: A case report. J. Med. Case Rep. 2016, 10, 197. [Google Scholar] [CrossRef]
- Ota, T.; Nakano, Y.; Nishi, M.; Matsuno, S.; Kawashima, H.; Nakagawa, T.; Takagi, T.; Wakasaki, H.; Furuta, H.; Nakano, T.; et al. A case of liver abscess caused by Edwardsiella tarda. Intern. Med. 2011, 50, 1439–1442. [Google Scholar] [CrossRef] [PubMed][Green Version]
- Ota, K.; Yamanoue, H.; Aizawa, N.; Suzuki, N.; Ota, K.; Takasu, A. Gastric submucosal abscess caused by Edwardsiella tarda infection: A case report. BMC Gastroenterol. 2020, 20, 299. [Google Scholar] [CrossRef]
- Ueda, H.; Tomioka, A.; Higashiyama, M.; Kimoto, Y.; Oguro, T.; Okazaki, S.; Ayaki, K.; Yoshidome, Y.; Tahara, H.; Nishimura, H.; et al. Fulminant necrotizing fasciitis by Edwardsiella tarda in a patient with alcoholic liver cirrhosis: A case report. J. Infect. Chemother. 2024, 30, 343–347. [Google Scholar] [CrossRef] [PubMed]
- Duman, M.; Satıcıoğlu, I.B.; Janda, J.M. A review of the industrial importance, common bacterial diseases, and zoonotic risks of freshwater aquarium fish. Vector Borne Zoonotic Dis. 2024, 24, 69–85. [Google Scholar] [CrossRef] [PubMed]
- Singh, B.R. Multiple drug resistant Edwardsiella tarda and Edwardsiella hoshinae in an integrated fish-pig-duck farm and down colony in Jharnapani, Nagaland. Environ. Sci. Med. 2014, 12446517. [Google Scholar]
- Farmer, J.J., III; Mc Whorter, A.C.; Genus, X. Edwardsiella. In Bergey’s Manual of Systematic Bacteriology; Krieg, N.R., Holt, J.G., Eds.; Williams and Wilkins: Baltimore, MD, USA, 1984; pp. 486–491. [Google Scholar]
- Singh, I.M.; Singh, S.; McMurphy, M.A.; Crupper, S.S.; Mills-Robertson, F.; Applegate, R.D. Antibiotic susceptibility of Edwardsiella hoshinae isolated from northern bobwhite quail (Colinus virginianus). Vet. Rec. 2004, 155, 29. [Google Scholar] [CrossRef]
- Mohanty, B.R.; Sahoo, P.K. Edwardsiellosis in fish: A brief review. J. Biosci. 2007, 32, 1331–1344. [Google Scholar] [CrossRef]
- Hawke, J.P.; Khoo, L.H. Infectious diseases. Biol. Cult. Channel Catfish 2004, 34, 387–443. [Google Scholar]
- Griffin, M.J.; Greenway, T.E.; Wise, D.J. Edwardsiella spp. In Fish Viruses and Bacteria: Pathobiology and Protection; Woo, P.T.K., Cipriano, R.C., Eds.; CABI: Wallingford, UK, 2017; pp. 190–210. [Google Scholar]
- Wyatt, L.E.; Nickelson, R., 2nd; Vanderzant, C.A.R.L. Edwardsiella tarda in freshwater catfish and their environment. Appl. Environ. Microbiol. 1979, 38, 710–714. [Google Scholar] [CrossRef]
- Arambulo, P.V.; Westerlund, N.C.; Sarmiento, R.V. On the isolation of human enteric organisms from the bile of pigs and cattle. Acta Medica Philipp. 1968, 5, 84–86. [Google Scholar]
- Tacal JVJ, Menez CF: The isolation of Edwardsiella tarda from a dog. Philipp. J. Vet. Med. 1969, 7, 143–145.
- Nucci, C.; Da Silveira, W.D.; da Silva Correa, S.; Nakazato, G.; Bando, S.Y.; Ribeiro, M.A.; De Castro, A.P. Microbiological comparative study of isolates of Edwardsiella tarda isolated in different countries from fish and humans. Vet. Microbiol. 2002, 89, 29–39. [Google Scholar] [CrossRef] [PubMed]
- Adanech, B.H.; Temesgen, K.G. Isolation and identification of Escherichia coli and Edwardsiella tarda from fish harvested for human consumption from Zeway Lake, Ethiopia. Afr. J. Microbiol. Res. 2018, 12, 76–480. [Google Scholar] [CrossRef]
- Hawke, J.P.; Kent, M.; Rogge, M.; Baumgartner, W.; Wiles, J.; Shelley, J.; Savolainen, L.C.; Wagner, R.; Murray, K.; Peterson, T.S. Edwardsiellosis caused by Edwardsiella ictaluri in laboratory populations of zebrafish Danio rerio. J. Aquat. Anim. Health 2013, 25, 171–183. [Google Scholar] [CrossRef] [PubMed]
- Loch, T.P.; Hawke, J.P.; Reichley, S.R.; Faisal, M.; Del Piero, F.; Griffin, M.J. Outbreaks of edwardsiellosis caused by Edwardsiella piscicida and Edwardsiella tarda in farmed barramundi (Lates calcarifer). Aquaculture 2017, 481, 202–210. [Google Scholar] [CrossRef]
- Xu, T.; Zhang, X.H. Edwardsiella tarda: An intriguing problem in aquaculture. Aquaculture 2014, 431, 129–135. [Google Scholar] [CrossRef]
- Nagy, E.; Fadel, A.; Al-Moghny, F.A.; Ibrahim, M.S. Isolation, identification, and pathogenicity characterization of Edwardsiella tarda Isolated from Oreochromis niloticus fish farms in Kafr-Elshiekh, Egypt. Alex. J. Vet. Sci. 2018, 57, 171–179. [Google Scholar] [CrossRef]
- Butar-Butar, O.D.; Suryanto, D.; Ilyas, S. Detection of Edwardsiella tarda infection of catfish (Clarias gariepinus) in central Tapanuli Regency, North Sumatra, Indonesia. IOSR J. Agric. Vet. Sci. 2020, 13, 6–13. [Google Scholar]
- Waltman, W.D.; Shotts, E.B.; Hsu, T.C. Biochemical and enzymatic characterization of Edwardsiella tarda from the United States and Taiwan. Fish Pathol. 1986, 21, 1–8. [Google Scholar] [CrossRef]
- Ali, M.H.; Chowdhury, F.S.; Ashrafuzzaman, M.; Al Nayem, M. Identification, pathogenicity, antibiotic and herbal sensitivity of Edwardsiella tarda causing fish disease in Bangladesh. Curr. Res. Microbiol. Biotechnol. 2014, 2, 292–297. [Google Scholar]
- Clavijo, A.M.; Conroy, G.; Conroy, D.A.; Santander, J.; Aponte, F. First report of Edwardsiella tarda from tilapias in Venezuela. Bull. Eur. Ass. Fish Pathol. 2002, 22, 280–282. [Google Scholar]
- Nantongo, M.; Mkupasi, E.M.; Byarugaba, D.K.; Wamala, S.P.; Mdegela, R.H.; Walakira, J.K. Molecular characterization and antibiotic susceptibility of Edwardsiella tarda isolated from farmed Nile tilapia and African catfish from Wakiso, Uganda. Uganda J. Agric. Sci. 2019, 19, 51–64. [Google Scholar] [CrossRef]
- Dong, H.T.; Senapin, S.; Jeamkunakorn, C.; Nguyen, V.V.; Nguyen, N.T.; Rodkhum, C.; Khunrae, P.; Rattanarojpong, T. Natural occurrence of edwardsiellosis caused by Edwardsiella ictaluri in farmed hybrid red tilapia (Oreochromis sp.) in Southeast Asia. Aquaculture 2019, 499, 17–23. [Google Scholar] [CrossRef]
- Ogunleye, S.C.; Ishola, O.O.; Olatoye, I.O.; Adedeji, O.B. Detection and antibiogram of Edwardsiella tarda from Oreochromis niloticus (Tilapia) obtained from selected farms in Ibadan, Nigeria. J. Food Safe. Hyg. 2020, 6, 38–46. [Google Scholar]
- Shafiei, S.; Viljamaa-Dirks, S.; Sundell, K.; Heinikainen, S.; Abayneh, T.; Wiklund, T. Recovery of Edwardsiella piscicida from farmed whitefish, Coregonus lavaretus (L.), in Finland. Aquaculture 2016, 454, 19–26. [Google Scholar] [CrossRef]
- Oh, W.T.; Jun, J.W.; Kim, H.J.; Giri, S.S.; Yun, S.; Kim, S.G.; Kim, S.W.; Kang, J.W.; Han, S.J.; Kwon, J.; et al. Characterization and pathological analysis of a virulent Edwardsiella anguillarum strain isolated from Nile tilapia (Oreochromis niloticus) in Korea. Front. Vet. Sci. 2020, 7, 14. [Google Scholar] [CrossRef] [PubMed]
- Jung, W.J.; Kwon, J.; Giri, S.S.; Kim, S.G.; Kim, S.W.; Kang, J.W.; Lee, S.B.; Lee, Y.M.; Oh, W.T.; Jun, J.W.; et al. Isolation and characterization of a highly virulent Edwardsiella piscicida strain responsible for mass mortality in marbled eel (Anguilla marmorata) cultured in Korea. Aquaculture 2022, 555, 738199. [Google Scholar] [CrossRef]
- Wang, Y.; Zhai, S.; Wan, Q.; Xu, M.; Chen, M.; Guo, S. Pathogenicity of Edwardsiella anguillarum to American eels (Anguilla rostrata) and RNA-seq analysis of host immune response to the E. anguillarum infection. Fish Shellfish Immunol. 2023, 141, 109042. [Google Scholar] [CrossRef] [PubMed]
- Frerichs, G.N. Bacterial diseases of marine fish. Vet. Rec. 1989, 125, 315–318. [Google Scholar] [CrossRef]
- Sakazaki, R.; Tamura, K. Priority of the specific epithet anguillimortiferum over the specific epithet tarda in the name of the organism presently known as Edwardsiella tarda. Int. J. Syst. Evol. Microbiol. 1975, 25, 219–220. [Google Scholar] [CrossRef]
- Roggendorf, M.; Müller, H.E. Enterobacteria of reptiles (author’s transl). Zentralblatt Fur Bakteriol. Parasitenkd. Infekt. Und Hygiene. Erste Abt. Originale. Reihe A Med. Mikrobiol. Und Parasitol. 1976, 236, 22–35. [Google Scholar]
- Kourany, M.; Vasquez, M.A.; Saenz, R. Edwardsiellosis in man and animals in Panamá: Clinical and epidemiological characteristics. Am. J. Trop. Med. Hyg. 1977, 26, 1183–1190. [Google Scholar] [CrossRef] [PubMed]
- Johnston, M.A.; Porter, D.E.; Scott, G.I.; Rhodes, W.E.; Webster, L.F. Isolation of faecal coliform bacteria from the American alligator (Alligator mississippiensis). J. Appl. Microbiol. 2010, 108, 965–973. [Google Scholar] [CrossRef] [PubMed]
- Charruau, P.; Pérez-Flores, J.; Pérez-Juárez, J.G.; Cedeño-Vázquez, J.R.; Rosas-Carmona, R. Oral and cloacal microflora of wild crocodiles Crocodylus acutus and C. moreletii in the Mexican Caribbean. Dis. Aquat. Org. 2012, 98, 27–39. [Google Scholar] [CrossRef] [PubMed]
- Buenviaje, G.N.; Ladds, P.W.; Melville, L.; Manolis, S.C. Disease-husbandry associations in farmed crocodiles in Queensland and the Northern Territory. Aust. Vet. J. 1994, 71, 165–173. [Google Scholar] [CrossRef] [PubMed]
- Guo, G.; Jiang, J.; Yang, N.; Wang, P.; Zhang, L.; Wang, Y.; Zeng, J.; Zheng, J. An investigation of sudden death in farmed infant Siamese crocodiles during winter and spring in Hainan, China. Indian J. Anim. Res. 2018, 52, 1058–1062. [Google Scholar]
- Rehman, M.N.U.; Wang, Y.; Pan, J.; Han, Y.; Yang, N.; Wang, X.; Fan, L.; Li, Q.; Yin, F.; Wang, P.; et al. Histological and molecular characterization of Edwardsiella tarda infection in Siamese crocodile (Crocodylus siamensis) hatchlings. Aquaculture 2021, 535, 736367. [Google Scholar] [CrossRef]
- Koeboelkuti, L.B.; Czirjak, G.A.; Tenk, M.; Szakacs, A.; Kelemen, A.; Spinu, M. Edwardsiella tarda associated subcutaneous abscesses in a captive grass snake Kafkas Üniv. Vet. Fak. Derg. 2013, 19, 1061–1063. [Google Scholar]
- Leotta, G.A.; Piñeyro, P.; Serena, S.; Vigo, G.B. Prevalence of Edwardsiella tarda in Antarctic wildlife. Polar Biol. 2009, 32, 809–812. [Google Scholar] [CrossRef]
- Miniero Davies, Y.; Xavier de Oliveira, M.G.; Paulo Vieira Cunha, M.; Soares Franco, L.; Pulecio Santos, S.L.; Zanolli Moreno, L.; Túlio de Moura Gomes, V.; Zanolli Sato, M.I.; Schiavo Nardi, M.; Micke Moreno, A.; et al. Edwardsiella tarda outbreak affecting fishes and aquatic birds in Brazil. Vet. Q. 2018, 38, 99–105. [Google Scholar] [CrossRef]
- Farmer, J.J., III; Davis, B.R.; Hickman-Brenner, F.W.; McWhorter, A.; Huntley-Carter, G.P.; Asbury, M.A.; Riddle, C.; Wathen-Grady, H.G.; Elias, C.; Fanning, G.R.; et al. Biochemical identification of new species and biogroups of Enterobacteriaceae isolated from clinical specimens. J. Clin. Microbiol. 1985, 21, 46–76. [Google Scholar] [CrossRef] [PubMed]
- Farmer, J.J., III; Farmer, M.K.; Holmes, B. Chapter 51. The Enterobacteriaceae: General characteristics. In Topley and Wilson’s Microbiology and Microbial Infections, 10th ed.; Borriello, S.P., Murray, P.R., Funke, G.P., Eds.; Wiley: Hoboken, NJ, USA, 2006; pp. 1317–1359. [Google Scholar]
- Janda, J.M.; Abbott, S.L. Unusual food-borne pathogens: Listeria monocytogenes, Aeromonas, Plesiomonas, and Edwardsiella species. Clin. Lab. Med. 1999, 19, 553–582. [Google Scholar] [CrossRef]
- Iveson, J.B. Enrichment procedures for the isolation of Salmonella, Arizona, Edwardsiella and Shigella from faeces. J. Hyg. Camb. 1973, 71, 349–361. [Google Scholar] [CrossRef] [PubMed][Green Version]
- Sechter, I.; Shmilovitz, M.; Altmann, G.; Seligmann, R.; Kretzer, B.; Braunstein, I.; Gerichter, C.B. Edwardsiella tarda isolated in Israel between 1961 and 1980. J. Clin. Microbiol. 1983, 17, 669–671. [Google Scholar] [CrossRef] [PubMed]
- Walton, D.T.; Abbott, S.L.; Janda, J.M. Sucrose-positive Edwardsiella tarda mimicking a biogroup 1 strain isolated from a patient with cholelithiasis. J. Clin. Microbiol. 1993, 31, 155–156. [Google Scholar] [CrossRef]
- Leung, M.J. Plesiomonas shigelloides and sucrose-positive Edwardsiella tarda bacteremia in a man with obstructive jaundice. Pathology 1996, 28, 68–69. [Google Scholar] [CrossRef]
- Ramanan, P.; Bryson, A.L.; Binnicker, M.J.; Pritt, B.S.; Patel, R. Syndromic panel-based testing in clinical microbiology. Clin. Microbiol. Rev. 2018, 31, e00024-17. [Google Scholar] [CrossRef]
- Janda, J.M.; Abbott, S.L. 16S rRNA gene sequencing for bacterial identification in the diagnostic laboratory: Pluses, perils, and pitfalls. J. Clin. Microbiol. 2007, 45, 2761–2764. [Google Scholar] [CrossRef]
- He, Y.; Li, H.; Lu, X.; Stratton, C.W.; Tang, Y.-W. Mass spectrometry Biotper system identifies enteric bacterial pathogens directly from colonies grown on selective stool culture media. J. Clin. Microbiol. 2010, 48, 3888–3892. [Google Scholar] [CrossRef]
- Reichley, S.R.; Ware, C.; Steadman, J.; Gaunt, P.S.; Garcia, J.C.; LaFrentz, B.R.; Thachil, A.; Waldbieser, G.C.; Stine, C.B.; Buján, N.; et al. Comparative phenotypic and genotypic analysis of Edwardsiella isolates from different hosts and geographic origins, with emphasis on isolates formerly classified as E. tarda, and evaluation of diagnostic methods. J. Clin. Microbiol. 2017, 55, 3466–3491. [Google Scholar] [CrossRef]
- Crumlish, M.; Dung, T.T.; Turnbull, J.F.; Ngoc, N.T.N.; Ferguson, H.W. Identification of Edwardsiella ictaluri from diseased freshwater catfish, Pangasius hypophthalmus (Sauvage), cultured in the Mekong Delta, Vietnam. J. Fish Dis. 2002, 25, 733–736. [Google Scholar] [CrossRef]
- Phillips, A.C.N.; Reichley, S.R.; Ware, C.; Griffin, M.J. Edwardsiella ictaluri infection in Pangasius catfish imported from West Bengal into the Southern Caribbean. J. Fish Dis. 2017, 40, 743–756. [Google Scholar] [CrossRef] [PubMed]
- Rogge, M.L.; Dubytska, L.; Jung, T.S.; Wiles, J.; Elkamel, A.A.; Rennhoff, A.; Oanh, D.T.H.; Thune, R.L. Comparison of Vietnamese and US isolates of Edwardsiella ictaluri. Dis. Aquat. Org. 2013, 106, 17–29. [Google Scholar] [CrossRef] [PubMed]
- Kalindamar, S.; Kordon, A.O.; Abdelhamed, H.; Tan, W.; Pinchuk, L.M.; Karsi, A. Edwardsiella ictaluri evpP is required for colonization of channel catfish ovary cells and necrosis in anterior kidney macrophages. Cell. Microbiol. 2020, 22, e13135. [Google Scholar] [CrossRef] [PubMed]
- Mitchell, A.J.; Goodwin, A.E. The isolation of Edwardsiella ictaluri with a limited tolerance for aerobic growth from channel catfish. J. Aquat. Anim. Health 2000, 12, 297–300. [Google Scholar] [CrossRef]
- Plumb, J.A.; Vinitnantharat, S. Biochemical, biophysical, and serological homogeneity of Edwardsiella ictaluri. J. Aquat. Anim. Health 1989, 1, 51–56. [Google Scholar] [CrossRef]
- Iwanowicz, L.R.; Griffin, A.R.; Cartwright, D.D.; Blazer, V.S. Mortality and pathology in brown bullheads Amieurus nebulosus associated with a spontaneous Edwardsiella ictaluri outbreak under tank culture conditions. Dis. Aquat. Org. 2006, 70, 219–225. [Google Scholar] [CrossRef] [PubMed]
- Panangala, V.S.; Shoemaker, C.A.; McNulty, S.T.; Arias, C.R.; Klesius, P.H. Intra-and interspecific phenotypic characteristics of fish-pathogenic Edwardsiella ictaluri and E. tarda. Aquacult. Res. 2006, 37, 49–60. [Google Scholar] [CrossRef]
- Williams, M.L.; Lawrence, M.L. Verification of an Edwardsiella ictaluri-specific diagnostic PCR. Lett. Appl. Microbiol. 2010, 50, 153–157. [Google Scholar] [CrossRef]
- Sakai, T.; Yuasa, K.; Sano, M.; Iida, T. Identification of Edwardsiella ictaluri and E. tarda by species-specific polymerase chain reaction targeted to the upstream region of the fimbrial gene. J. Aquat. Anim. Health 2009, 21, 124–132. [Google Scholar] [CrossRef]
- Geng, Y.; Wang, K.Y.; Li, C.W.; Ren, S.Y.; Zhou, Z.Y.; Liu, X.X.; Liu, X.F.; Lai, W.M.; Huang, X.L.; Chen, D.F. Isolation and characterization of Edwardsiella ictaluri from southern catfish, Silurus soldatovi meridionalis, (Chen) cultured in China. J. World Aquacult. Soc. 2013, 44, 273–281. [Google Scholar] [CrossRef]
- Ucko, M.; Colorni, A.; Dubytska, L.; Thune, R.L. Edwardsiella piscicida-like pathogen in cultured grouper. Dis. Aquat. Org. 2016, 121, 141–148. [Google Scholar] [CrossRef] [PubMed]
- Fogelson, S.B.; Petty, B.D.; Reichley, S.R.; Ware, C.; Bowser, P.R.; Crim, M.J.; Getchell, R.G.; Sams, K.L.; Marquis, H.; Griffin, M.J. Histologic and molecular characterization of Edwardsiella piscicida infection in largemouth bass (Micropterus salmoides). J. Vet. Diagn. Investig. 2016, 28, 338–344. [Google Scholar] [CrossRef] [PubMed]
- Fox, G.E.; Wisotzkey, J.D.; Jurtshuk Jr, P. How close is close: 16S rRNA sequence identity may not be sufficient to guarantee species identity. Int. J. Syst. Evol. Microbiol. 1992, 42, 166–170. [Google Scholar] [CrossRef] [PubMed]
- Mun Huang, W. Bacterial diversity based on type II DNA topoisomerase genes. Annu. Rev. Genet. 1996, 30, 79–107. [Google Scholar] [CrossRef]
- Griffin, M.J.; Quiniou, S.M.; Cody, T.; Tabuchi, M.; Ware, C.; Cipriano, R.C.; Mauel, M.J.; Soto, E. Comparative analysis of Edwardsiella isolates from fish in the eastern United States identifies two distinct genetic taxa amongst organisms phenotypically classified as E. tarda. Vet. Microbiol. 2013, 165, 358–372. [Google Scholar] [CrossRef] [PubMed]
- Griffin, M.J.; Ware, C.; Quiniou, S.M.; Steadman, J.M.; Gaunt, P.S.; Khoo, L.H.; Soto, E. Edwardsiella piscicida identified in the southeastern USA by gyrB sequence, species-specific and repetitive sequence-mediated PCR. Dis. Aquat. Org. 2014, 108, 23–35. [Google Scholar] [CrossRef]
- Griffin, M.J.; Reichley, S.R.; Greenway, T.E.; Quiniou, S.M.; Ware, C.; Gao, D.X.; Gaunt, P.S.; Yanong, R.P.E.; Pouder, D.B.; Hawke, J.P.; et al. Comparison of Edwardsiella ictaluri isolates from different hosts and geographic origins. J. Fish Dis. 2016, 39, 947–969. [Google Scholar] [CrossRef]
- Wang, I.K.; Kuo, H.-L.; Lin, C.-L.; Chang, H.-Y.; Chuang, F.R.; Lee, M.-H. Extraintestinal manifestations of Edwardsiella tarda infection. J. Clin. Pract. 2005, 8, 917–921. [Google Scholar] [CrossRef]
- Nelson, J.J.; Nelson, C.A.; Carter, J.E. Extraintestinal manifestations of Edwardsiella tarda infection: A 10-year retrospective review. J. La. State Med. Soc. 2009, 161, 103–106. [Google Scholar]
- Desenclos, J.-C.A.; Conti, L.; Junejo, S.; Klontz, K.C. A cluster of Edwardsiella tarda infection in a day-care center in Florida. J. Infect. Dis. 1990, 162, 782–783. [Google Scholar] [CrossRef] [PubMed]
- Chatty, H.B.; Gavan, T.L. Edwardsiella tarda—Identification and clinical significance. Cleve. Clin. Q. 1968, 35, 223–228. [Google Scholar] [CrossRef] [PubMed]
- Marsh, P.K.; Gorbach, S.L. Invasive enterocolitis caused by Edwardsiella tarda. Gastroenterology 1982, 82, 336–338. [Google Scholar] [CrossRef] [PubMed]
- Onogawa, T.; Terayama, T.; Zen-Yoji, H. Distribution of Edwardsiella tarda hydrogen sulfide-producing Escherichia coli in healthy persons. Kansenshogaku Zasshi 1976, 50, 10–17. [Google Scholar] [CrossRef] [PubMed]
- Bhat, P.; Myers, R.M.; Carpenter, K.P. Edwardsiella rarda in a study of juvenile diarrhoea. J. Hyg. Camb. 1967, 68, 293–298. [Google Scholar] [CrossRef] [PubMed]
- Gilman, R.H.; Madasamy, M.; Gan, E.; Mariappan, M.; Davis, C.E.; Kyser, K.A. Edwardsiella tarda in jungle diarrhoea and a possible association with Entamoeba histolytica. Southeast Asian J. Trop. Med. Public Health 1971, 2, 186–189. [Google Scholar] [PubMed]
- Makulu, A.; Gatti, F.; Vandepitte, J. Edwardsiella tarda infections in Zaire. Ann. Soc. Belge Méd. Trop. 1972, 53, 165–172. [Google Scholar]
- Sydorchuk, A.S.; Bogachyk, N.A.; Venhlovska, Y.V. Clinical case of edwardsiellosis in Ukraine. Wiad. Lek. 2021, 74, 165–167. [Google Scholar] [CrossRef]
- Chida, R.; Iio, K.; Kaizuka, H.; Hirai, Y.; Ishida, Y.; Yamanaka, G. Chronic diarrhea associated with Edwardsiella tarda gastroenteritis. Pediatr. Infect. Dis. J. 2022, 41, e440–e442. [Google Scholar] [CrossRef]
- Clarridge, J.E.; Musher, D.M.; Fainstein, V.; Wallace, R.J., Jr. Extraintestinal human infection caused by Edwardsiella tarda. J. Clin. Microbiol. 1980, 11, 511–514. [Google Scholar] [CrossRef]
- Bui, A.; Cortese, C.; Libertin, C.R.; Porter, I.E., II. Minimal change disease and subacute interstitial nephritis in association with Edwardsiella tarda gastroenteritis following oyster consumption. IDCases 2021, 25, e01236. [Google Scholar] [CrossRef] [PubMed]
- Arya, A.V.; Rostom, A.; Dong, W.-F.; Flynn, A.N. Crohn’s disease exacerbation induced by Edwardsiella tarda gastroenteritis. Case Rep. Gastroenterol. 2011, 5, 623–627. [Google Scholar] [CrossRef] [PubMed]
- Li, A.K.; Barton, M.; Delport, J.A.; Ashok, D. Edwardsiella tarda infection triggering acute relapse in pediatric Crohn’s disease. Case Rep. Infect. Dis. 2019, 2019, 2094372. [Google Scholar] [CrossRef] [PubMed]
- Koido, S.; Ohkusa, T.; Kato, K.; Shimamoto, N.; Takakura, K.; Odahara, S.; Tsukinaga, S.; Mitobe, J.; Yukawa, T.; Kajihara, M.; et al. Edwardsiella tarda superinfection in replapse of ulcerative colitis. J. Clin. Gastroenterol. 2014, 48, 191–193. [Google Scholar] [CrossRef] [PubMed]
- Shankar, U.; Chitra, G.; Mandal, J.; Mohan, P.; Hamide, A. Exacerbation of ulcerative colitis due to Edwardsiella tarda infection. East. J. Med. Sci. 2017, 2, 47–48. [Google Scholar] [CrossRef]
- Adepoju, A.; Adelja, A.O.; Amoo, A.; Orimadegun, A.E.; Akinyinka, O.O. Edwardsiella ictalurid, an unusual cause of bacteraemia in a Nigerian child with acute bloody diarrhoea. Int. J. Res. Med. Sci. 2021, 9, 3175–3178. [Google Scholar] [CrossRef] [PubMed]
- Kamiyama, S.; Kuriyama, A.; Hashimoto, T. Edwardsiella tarda bacteremia, Okayama, Japan, 2005–2016. Emerg. Infect. Dis. 2019, 25, 1817–1823. [Google Scholar] [CrossRef]
- LeBlond, L. Catfish bite case report. Wilderness Environ. Med. 2019, 30, 291–294. [Google Scholar] [CrossRef] [PubMed]
- Bakirova, G.H.; Alharthy, A.; Corcione, S.; Aletreby, W.T.; Mady, A.F.; De Rosa, F.G.; Karakitsos, D. Fulminant septic shock due to Edwardsiella tarda infection associated with multiple liver abscesses: A case report and review of the literature. J. Med. Case Rep. 2020, 14, 144. [Google Scholar] [CrossRef]
- Peravali, R.; Muddassir, K. A rare but fatal waterborne infection. Am. J. Med. 2021, 134, e329–e330. [Google Scholar] [CrossRef]
- Osiri, M.; Tantawichien, T.; Deesomchock, U. Edwardsiella tarda bacteremia and septic arthritis in a patient with diabetes mellitus. Southeast Asian J. Trop. Med. Public Health 1997, 28, 669–672. [Google Scholar] [PubMed]
- John, A.M.; Prakash, J.A.J.; Simon, E.G.; Thomas, N. Edwardsiella tarda sepsis with multiples liver abscesses in a patient with Cushing’s syndrome. Indian J. Med. Microbiol. 2012, 30, 352–354. [Google Scholar] [CrossRef] [PubMed]
- An, L.; Chan, J.L.; Nguyen, M.; Yang, S.; Deville, J.G. Case report: Disseminated Edwardsiella tarda infection in an immunocompromised patient. Front. Cell. Infect. Microbiol. 2023, 13, 1292768. [Google Scholar] [CrossRef] [PubMed]
- Mowbray, E.E.; Buck, G.; Humbaugh, K.E.; Marshall, G.S. Maternal colonization and neonatal sepsis caused by Edwardsiella tarda. Pediatrics 2003, 111, e296–e298. [Google Scholar] [CrossRef] [PubMed]
- Haenen, O.L.M.; Evans, J.J.; Berthe, F. Bacterial infections from aquatic species: Potential for and prevention of contact zoonoses. Rev. Sci. Tech. Off. Int. Epiz. 2013, 32, 497–507. [Google Scholar] [CrossRef] [PubMed]
- Jnaneshwara, K.B.; Patil, A.B.; Kalkutkar, A.; Aaftab Ahmed, G.P.; Sheethal, S. Edwardsiella tarda: An uncommon causative agent of cellulitis. Int. J. Curr. Microbiol. Appl. Sci. 2016, 5, 627–630. [Google Scholar] [CrossRef][Green Version]
- Pham, K.; Wu, Y.; Turett, G.; Prasad, N.; Yung, L.; Rodriguez, G.D.; Segal-Maurer, S.; Urban, C.; Yoon, J. Edwardsiella tarda, a rare human pathogen isolated from a perihepatic abscess: Implications of transient versus long term colonization of the gastrointestinal tract. IDCases 2021, 26, e01283. [Google Scholar] [CrossRef] [PubMed]
- Hargreaves, J.E.; Lucey, D.R. Life-threatening Edwardsiella tarda soft-tissue infection associated with catfish puncture wound. J. Infect. Dis. 1990, 162, 1416–1417. [Google Scholar] [CrossRef] [PubMed]
- Crosby, S.N.; Snoddy, M.C.; Arkinson, C.T.; Lee, D.H.; Weikert, D.R. Upper extremity myonecrosis caused by Edwardsiella tarda resulting in transhumeral amputation: Case report. J. Hand Surg. Am. 2013, 38, 129–132. [Google Scholar] [CrossRef]
- Vartian, C.V.; Septimus, E.J. Soft-tissue infection caused by Edwardsiella tarda and Aeromonas hydrophila. J. Infect. Dis. 1990, 161, 816. [Google Scholar] [CrossRef]
- Ohara, Y.; Kikuchi, O.; Goto, T.; Yoshida, T.; Mori, H.; Matsueda, K.; Yamamoto, H. Successful treatment of a patient with sepsis and liver abscess caused by Edwardsiella tarda. Intern. Med. 2012, 51, 2813–2817. [Google Scholar] [CrossRef]
- Anno, T.; Kobayashi, N. Infected subdural hematoma caused by Edwardsiella tarda. J. Rural Med. 2018, 13, 86–88. [Google Scholar] [CrossRef][Green Version]
- Takeuchi, H.; Fujita, Y.; Ogawa, H.; Shiomi, K.; Toyokawa, Y.; Yamamoto, T.; Furikawa, T.; Ebisu, T. Multiple brain abscesses in neonate caused by Edwardsiella tarda. Neurol. Med. Chir. 2009, 49, 85–89. [Google Scholar] [CrossRef]
- Makino, T.; Sugano, I.; Kamitsukasa, I. An autopsy case of Edwardsiella tarda meningoencephalitis. Case Rep. Neurol. 2018, 10, 252–260. [Google Scholar] [CrossRef] [PubMed]
- Vohra, K.; Torrijos, E.; Jhaveri, R.; Gordon, H. Neonatal sepsis and meningitis caused by Edwardsiella tarda. Pediatr. Infect. Dis. J. 1988, 7, 814–815. [Google Scholar] [PubMed]
- Leão, R.S.; Santos, R.M.R.; Albuquerque, A.L.M.C.; Carvalho-Assef, A.P.D.A.; Marques, E.A. Neonatal sepsis and meningitis caused by Edwardsiella tarda isolates belonging to the same clone: A case report. Int. J. Microbiol. Res. 2015, 7, 613–615. [Google Scholar]
- Hara, C.; Tanaka, T.; Nishiwada, S.; Kirihataya, Y.; Toshimura, A. Acute cholecystitis with sepsis due to Edwardsiella tarda: A case report. Surg. Case Rep. 2023, 9, 184. [Google Scholar] [CrossRef]
- Kolke, M.; Doi, T.; Iba, Y.; Yuda, S. Edwardsiella tarda native valvce infective endocarditis in a young and non-immunocompromised host: A case report. Am. J. Case Rep. 2021, 22, e932387. [Google Scholar]
- Ng, Q.X.; Seng, C.; Chan, F.Z.Y.; Yeo, W.S. Zoonosis: An unusual case of chronic osteomyelitis. Singap. Med. J. 2019, 60, 379–381. [Google Scholar] [CrossRef] [PubMed]
- Higashigawa, M.; Ito, M.; Nashida, Y. Edwardsiella tarda is an important causative agent of maternal-fetal infections in pregnant women: A case report and Japanese literature review. Jpn. J. Infect. Dis. 2023, 76, 80–83. [Google Scholar] [CrossRef]
- Yu, J.H.; Han, J.J.; Park, K.S.; Park, K.H.; Park, S.W. Edwardsiella tarda infection in Korean catfish, Silurus asotus, in a Korean fish farm. Aquac. Res. 2009, 41, 19–26. [Google Scholar] [CrossRef]
- Park, S.B.; Aoki, T.; Jung, T.S. Pathogenesis of and strategies for preventing Edwardsiella tarda infection in fish. Vet. Res. 2012, 43, 67. [Google Scholar] [CrossRef]
- Xiao, J.; Wang, Q.; Liu, Q.; Wang, X.; Liu, H.; Zhang, Y. Isolation and identification of fish pathogen Edwardsiella tarda from mariculture in China. Aquac. Res. 2008, 40, 13–17. [Google Scholar] [CrossRef]
- Shotts, E.B.; Blazer, V.S.; Waltman, W.D. Pathogenesis of experimental Edwardsiella ictaluri infections in channel catfish (Ictalurus punctatus). Can. J. Fish. Aquat. Sci. 1986, 43, 36–42. [Google Scholar] [CrossRef]
- Sakai, T.; Kamaishi, T.; Sano, M.; Tensha, K.; Arima, T.; Iida, Y.; Nagai, T.; Nakai, T.; Iida, T. Outbreaks of Edwardsiella ictaluri infection in ayu Plecoglossus altivelis in Japanese rivers. Fish Pathol. 2008, 43, 152–157. [Google Scholar] [CrossRef][Green Version]
- Dung, T.T.; Haesebrouck, F.; Tuan, N.A.; Sorgeloos, P.; Baele, M.; Decostere, A. Antimicrobial susceptibility pattern of Edwardsiella ictaluri isolates from natural outbreaks of bacillary necrosis of Pangasianodon hypophthalmus in Vietnam. Microb. Drug Resist. 2008, 14, 311–316. [Google Scholar] [CrossRef] [PubMed]
- Xiao, Y.; Wu, L.; He, L.; Tang, Y.; Guo, S.; Zhai, S. Transcriptomic analysis using dual RNA sequencing revealed a Pathogen–Host interaction after Edwardsiella anguillarum infection in European eel (Anguilla anguilla). Fish Shellfish Immunol. 2022, 120, 745–757. [Google Scholar] [CrossRef] [PubMed]
- Dong, H.T.; Nguyen, V.V.; Phiwsaiya, K.; Gangnonngiw, W.; Withyachumnarnkul, B.; Rodkhum, C.; Senapin, S. Concurrent infections of Flavobacterium columnare and Edwardsiella ictaluri in striped catfish, Pangasianodon hypophthalmus in Thailand. Aquaculture 2015, 448, 142–150. [Google Scholar] [CrossRef]
- Cheng, L.W.; Lee, H.C.; Huang, Q.Y.; Huang, W.R.; Wang, P.C.; Chen, S.C. An emerging pathogen found in farm-cultured fourfinger threadfin (Eleutheronema tetradactylum), Edwardsiella piscicida, its genetic profile, virulent genes, and pathogenicity. Aquaculture 2024, 585, 740682. [Google Scholar] [CrossRef]
- Uhland, F.C.; Hélie, P.; Higgins, R. Infections of Edwardsiella tarda among brook trout in Quebec. J. Aquat. Anim. Health 2000, 12, 74–77. [Google Scholar] [CrossRef]
- Padros, F.; Zarza, C.; Dopazo, L.; Cuadrado, M.; Crespo, S. Pathology of Edwardsiella tarda infection in turbot, Scophthalmus maximus (L.). J. Fish Dis. 2006, 29, 87–94. [Google Scholar] [CrossRef] [PubMed]
- Kodama, H.; Murai, T.; Nakanishi, Y.; Yamamoto, F.; Mikami, T.; Izawa, H. Bacterial infection which produces high mortality in cultured Japanese flounder (Paralichthys olivaceus) in Hokkaido. Jpn. J. Vet. Res. 1987, 35, 227–234. [Google Scholar] [PubMed]
- Nowakiewicz, A.; Ziółkowska, G.; Zięba, P.; Dziedzic, B.M.; Gnat, S.; Wójcik, M.; Dziedzic, R.; Kostruba, A. Aerobic bacterial microbiota isolated from the cloaca of the European pond turtle (Emys orbicularis) in Poland. J. Wildl. Dis. 2015, 51, 255–259. [Google Scholar] [CrossRef] [PubMed]
- Shin, D.M.; Hossain, S.; Wimalasena, S.H.M.P.; Heo, G.J. Antimicrobial resistance and virulence factors of Edwardsiella tarda isolated from pet turtles. Pak. Vet. J. 2017, 37, 85–89. [Google Scholar]
- Rehman, M.N.U.; Dawar, F.U.; Zeng, J.; Fan, L.; Feng, W.; Wang, M.; Yang, N.; Guo, G.; Zheng, J. Complete genome sequence analysis of Edwardsiella tarda SC002 from hatchlings of Siamese crocodile. Front. Vet. Sci. 2023, 10, 1140655. [Google Scholar] [CrossRef] [PubMed]
- Liang, Q.; Zhu, N.; Zheng, X.; Ding, X.; He, R.; Xu, H.; Cao, F.; Xue, H.; Zhou, F.; Zheng, T. Transcriptome analysis of immune responses and metabolic regulations of Chinese soft-shelled turtle (Pelodiscus sinensis) against Edwardsiella tarda infection. Fishes 2022, 7, 79. [Google Scholar] [CrossRef]
- Seo, M.G.; Eo, K.Y.; Kwak, D.; Kim, K.T. Bacterial Sepsis Associated with a Captive State Caused by Edwardsiella tarda in a Eurasian Brown Bear (Ursus arctos arctos). J. Vet. Clin. 2023, 40, 78–82. [Google Scholar] [CrossRef]
- Li, M.F.; Sun, L.; Li, J. Edwardsiella tarda evades serum killing by preventing complement activation via the alternative pathway. Fish Shellfish Immunol. 2015, 43, 325–329. [Google Scholar] [CrossRef] [PubMed]
- Darwish, A.; Plumb, J.A.; Newton, J.C. Histopathology and pathogenesis of experimental infection with Edwardsiella tarda in channel catfish. J. Aquat. Anim. Health 2000, 12, 255–266. [Google Scholar] [CrossRef]
- Pressley, M.E.; Phelan, P.E., III; Witten, P.E.; Mellon, M.T.; Kim, C.H. Pathogenesis and inflammatory response to Edwardsiella tarda infection in the zebrafish. Dev. Comp. Immunol. 2005, 29, 501–513. [Google Scholar] [CrossRef]
- Choe, Y.; Yu, J.E.; Park, J.; Park, D.; Oh, J.I.; Kim, S.; Moon, K.H.; Kang, H.Y. Goldfish, Carassius auratus, as an infection model for studying the pathogenesis of Edwardsiella piscicida. Vet. Res. Commun. 2017, 41, 289–297. [Google Scholar] [CrossRef] [PubMed]
- Wang, X.; Wang, F.; Chen, G.; Yang, B.; Chen, J.; Fang, Y.; Wang, K.; Hou, Y. Edwardsiella tarda induces enteritis in farmed seahorses (Hippocampus erectus): An experimental model and its evaluation. Fish Shellfish Immunol. 2020, 98, 391–400. [Google Scholar] [CrossRef]
- Reinhardt, J.F.; Fowlston, S.; Jones, J.; George, W.L. Comparative in vitro activities of selected antimicrobial agents against Edwardsiella tarda. Antimicrob. Agents Chemother. 1985, 27, 966–967. [Google Scholar] [CrossRef] [PubMed][Green Version]
- Clark, R.B.; Lister, P.D.; Janda, J.M. In vitro susceptibility of Edwardsiella tarda to 22 antibiotics and antibiotic-β-lactamase-inhibitor combinations. Diagn. Microbiol. Infect. Dis. 1991, 14, 173–175. [Google Scholar] [CrossRef] [PubMed]
- Stock, I.; Wiedemann, B. Natural antibiotic susceptibilities of Edwardsiella tarda, E. ictaluri, and E. hoshinae. Antimicrob. Agents Chemother. 2001, 45, 2245–2255. [Google Scholar] [CrossRef]
- Kawai, T.; Kusakabe, H.; Kobayashi, S.; Onodera, M. Ostemoyelitis due to trimethoprim/sulfamethoxazole-resistant Edwardsiella tarda infection in a patient with X-linked chronic granulomatous disease. Infection 2011, 39, 171–173. [Google Scholar] [CrossRef]
- CLSI. Performance Standards for Antimicrobial Susceptibility Testing, 33rd ed.; M100-Ed33; Clinical and Laboratory Standards Institute: Wayne, PA, USA, 2023; pp. 1–382. [Google Scholar]
- CLSI. Performance Standards for Antimicrobial Disk and Dilution Susceptibility Tests for Bacteria Isolated from Animals, 6th ed.; CLSI VET01Ed6E; Clinical and Laboratory Standards Institute: Wayne, PA, USA, 2023; pp. 1–144. [Google Scholar]
- Kusuda, R.; Kawai, K. Bacterial diseases of cultured marine fish in Japan. Fish Pathol. 1998, 33, 221–227. [Google Scholar] [CrossRef]
- Lo, D.Y.; Lee, Y.J.; Wang, J.H.; Kuo, H.C. Antimicrobial susceptibility and genetic characterisation of oxytetracycline-resistant Edwardsiella tarda isolated from diseased eels. Vet. Rec. 2014, 175, 203. [Google Scholar] [CrossRef]
- Meyer, F.; Bullock, G. Edwardsiella tarda, a new pathogen of channel catfish (Ictalurus punctatus). Appl. Microbiol. 1973, 25, 155–156. [Google Scholar] [CrossRef]
- Waltman, W.; Shotts, E. Antimicrobial susceptibility of Edwardsiella ictaluri. J. Wildl. Dis. 1986, 22, 173–177. [Google Scholar] [CrossRef]
- Castro, N.; Toranzo, A.E.; Barja, J.L.; Nunez, S.; Magarinos, B. Characterization of Edwardsiella tarda strains isolated from turbot, Psetta maxima (L.). J. Fish Dis. 2006, 29, 541–547. [Google Scholar] [CrossRef]
- Kim, A.; Lim, Y.; Kim, N.; Luan Nguyen, T.; Roh, H.J.; Park, C.I.; Han, H.J.; Jung, S.H.; Cho, M.Y.; Kim, D.H.; et al. A comparison of genotypic and phenotypic methods for analyzing the susceptibility to sulfamethoxazole and trimethoprim in Edwardsiella piscicida. Microb. Drug Resist. 2018, 24, 1226–1235. [Google Scholar] [CrossRef] [PubMed]
- Lim, Y.J.; Kim, D.H.; Roh, H.J.; Park, M.A.; Park, C.I.; Smith, P. Epidemiological cut-off values for disc diffusion data generated by standard test protocols from Edwardsiella tarda and Vibrio harveyi. Aquac. Int. 2016, 24, 1153–1161. [Google Scholar] [CrossRef]
- Chomel, B.B. Diseases transmitted by less common house pets. Microbiol. Spectr. 2015, 3, IOL5-0012-2015. [Google Scholar]
- Tan, R.J.S.; Lim, E.W. Occurrence of Edwardsiella tarda in the household lizard, Gecko gecko. Jpn. J. Med. Sci. Biol. 1977, 30, 321–323. [Google Scholar] [CrossRef]
- Litwin, C.M. Pet-transmitted infections: Diagnosis by microbiologic and immunologic methods. Pediatr. Infect. Dis. J. 2003, 22, 768–777. [Google Scholar] [CrossRef]
- Charruau, P.; Pérez-Juárez, J.G.; Medina, M.; de la Cruz, F.R.; Pérez-Flores, J. Bacterial flora of wild black (Ctenosaura similis Gray, 1831) and green (Iguana iguana Linnaeus, 1758) iguanas from a Mexican Caribbean atoll. Hepatol. Notes 2020, 13, 369–376. [Google Scholar]
- Shih, T.; Khan, S.; Shih, S.; Khachemoune, A. Fish pedicure: Review of its current dermatology applications. Cureus 2020, 12, e8936. [Google Scholar] [CrossRef] [PubMed]
- Day, M.J. Pet-related infections. Am. Fam. Physician 2016, 94, 794–802. [Google Scholar]
- Grant, S.; Olsen, C.W. Preventing zoonotic diseases in immunocompromised persons: The role of physicians and veterinarians. Emerg. Infect. Dis. 1999, 5, 159–163. [Google Scholar] [CrossRef]
- Ogunleye, S.C.; Ishola, O.O.; Olatoye, I.O.; Dada, O.E.; Adedeji, O.B. Edwardsiella tarda-The Despised Threat to Nigerian Aquaculture and Human Health: A Review. Agric. Rev. 2022, 43, 428–435. [Google Scholar] [CrossRef]
- Pirarat, N.; Kobayashi, T.; Katagiri, T.; Maita, M.; Endo, M. Protective effects and mechanisms of a probiotic bacterium Lactobacillus rhamnosus against experimental Edwardsiella tarda infection in tilapia (Oreochromis niloticus). Vet. Immunol. Immunopathol. 2006, 113, 339–347. [Google Scholar] [CrossRef] [PubMed]
- Swain, B.; Campodonico, V.A.; Curtiss, R., III. Recombinant Attenuated Edwardsiella piscicida Vaccine Displaying Regulated Lysis to Confer Biological Containment and Protect Catfish against Edwardsiellosis. Vaccines 2023, 11, 1470. [Google Scholar] [CrossRef] [PubMed]
- Mondal, H.; Thomas, J. A review on the recent advances and application of vaccines against fish pathogens in aquaculture. Aquac. Int. 2022, 30, 1971–2000. [Google Scholar] [CrossRef] [PubMed]
- Thinh, N.H.; Kuo, T.Y.; Hung, L.T.; Loc, T.H.; Chen, S.C.; Evensen, Ø.; Schuurman, H.J. Combined immersion and oral vaccination of Vietnamese catfish (Pangasianodon hypophthalmus) confers protection against mortality caused by Edwardsiella ictaluri. Fish Shellfish Immunol. 2009, 27, 773–776. [Google Scholar] [CrossRef] [PubMed]
- Ma, J.; Bruce, T.J.; Jones, E.M.; Cain, K.D. A review of fish vaccine development strategies: Conventional methods and modern biotechnological approaches. Microorganisms 2019, 7, 569. [Google Scholar] [CrossRef]

| Years | Event | Comment | Reference |
|---|---|---|---|
| 1959–1962 | Organisms first recovered and reported by Sakazaki and Tamura | “Asakusa group”; 153 isolates with similar characteristics | [2] |
| 1962 | Hoshina describes Paracolobactrum anguillimortiferum | Apparently an Edwardsiella but extant cultures are not available; no type strain deposited | [4] |
| 1964 | Report on “unidentified” group in family Enterobacteriaceae | Labeled the “Bartholomew” group | [3] |
| 1965 | New genus and species | Formal description of Edwardsiella and E. tarda; covered 37 different strains | [5] |
| 1967 | Detailed description of E. tarda strains | “Asakusa group”, 248 cultures; CDC E. tarda strains, 225 cultures | [2,10] |
| 1968 | First report of invasive disease caused by E. tarda | Meningitis in immunocompromised person | [8] |
| 1971 | Association with gastroenteritis in Thailanders | Of 23 persons (ages 8 mos–80 years;) with stool culture or rectal swab, 18 (78%) symptomatic, 4 asymptomatic and healthy, 1 with Shigella dysentery | [11] |
| Species | Type Strain | Nomenclature a | Major Source(s) b | Pathogenic for: | Ref. | ||
|---|---|---|---|---|---|---|---|
| Validated | Correct | Humans | Fish | ||||
| E. anguillimortifera | ATCC 15947T | Yes | No | Snakes | [19] | ||
| E. tarda | ATCC 15947T | Yes | Yes | Human | + | ± | [5] |
| E. hoshinae | ATCC 33379T (=CIP 78.56) | Yes | Yes | Birds, Reptiles | - | - | [19] |
| E. ictaluri | ATCC 33202T | Yes | Yes | Catfish | - | + | [20] |
| E. piscicida | CCUG 62929T (=NCIMB 14824T) | Yes | Yes | Fish | - | + | [21] |
| E. anguillarum | CCUG 64215T | Yes | Yes | Eels | - | ± | [22] |
| Category | Examples |
|---|---|
| Animal Exposure | Turtle, Ornamental fish |
| Aquatic Exposure | Bathing in village pond, Diving, Fall in brackish water, Fall in canal, Freshwater lakes, Immersion in lake (baptism), Near-drowning, Washed clothes in river, Swimming |
| Food Consumption | Ayu, Catfish, Ceviche, Eel, Fish (unspecified), Flounder, Horse mackerel, Meat (raw), Oysters, Sashimi, Seafood soup, Shark meat, Shrimp, Sushi, Tuna |
| Occupation/Vocation | Caregiver, Crabbing, Dock maintenance worker, Farmers, Fisherman, Fishmonger, Gardeners, Hobbyists, Veterinarians, Zoo staff |
| Trauma | Automobile accident, Brick, Catfish spine, Fishbone, Glass |
| Spencer et al. [57] | Hasegawa et al. [47] | Gilani et al. [56] | Tsuchiya et al. [58] | |
|---|---|---|---|---|
| Age/Sex | 8/M | 25/F | 4/F | 77/M |
| Comorbid conditions | Renal transplant | Sigmoid sinus thrombosis | None | Thoracic spondylitis, diabetes, prostate and pancreatic cancer |
| Risk factors/Mode of transmission | Playing in aquarium water with pet goldfish | Had a goldfish and a turtle | Goldfish in tank (died); hand in aquarium multiple times | Taking care of goldfish before admission |
| Symptoms | Weight loss, abdominal cramping, bloody stools | Intrauterine infection | Fever, dysuria | Back pain |
| Duration | 3 weeks | Not available | 1 week | Several weeks |
| Diagnosis | Gastroenteritis | Bacteremia | Urinary tract infection | Thoracic spondylitis Sepsis |
| Positive culture(s) | Stool | Blood | Urine (>105 CFU) | Blood, urine, abscess |
| Concurrent organisms | None | None | None | None |
| Outcome | Resolved | Resolved | Resolved | Resolved |
| Character | Enterobacteriaceae | The Genus Edwardsiella | Exceptions |
|---|---|---|---|
| Gram-negative rod | + | + | None |
| Facultative metabolism | + | + | None |
| Possession of the ECA a | + | + | None |
| Spore formation | - | - | None |
| Cytochrome oxidase | - | - | None |
| Catalase | + | + | None |
| Nitrate reductase | + | + | None |
| Fermentation of D-glucose | + | + | E. ictaluri |
| Fermentation of D-xylose | + | - | None |
| Property | Biotypes | ||
|---|---|---|---|
| Wild Type | Biogroup 1 | “Biogroup 2” | |
| Indole production | + | + | + |
| H2S production | + | - a | - a |
| Fermentation of: | |||
| D-mannitol | - | + | - |
| L-arabinose | - | + | - |
| Sucrose | + | + | + |
| Tetrathionate reduction | + | - | ND |
| Present in human clinical specimens | + | + b | + |
| Human pathogen | + | (+) b | + |
| Property | Species | ||
|---|---|---|---|
| E. ictaluri | E. piscicida | E. tarda | |
| Indole production | - | + | + |
| H2S production | - | + | + |
| Motility (25 °C) | - | + | + |
| Motility (37 °C) | - | + | + |
| Growth (37 °C) | - | + | + |
| Growth (42 °C) | - | - | + |
| RBC hemolysis | alpha | beta | beta |
| Methyl red | - | + | + |
| Malonate | - | - | - |
| Fermentation of: | |||
| Sucrose | - | - | - |
| Trehalose | - | - | - |
| D-mannitol | - | v | v |
| Arabinose | - | v | v |
| Agent | Mortality Rate | Fish Species | Water Temperature | Year | Region/Ref. |
|---|---|---|---|---|---|
| E. ictaluri | 40–50% | Hybrid red tilapia juveniles | 25–30 °C | 2016 | Northern Vietnam [84] |
| E. piscicida and E. tarda | ~1.0% | Barramundi | ~28 °C | 2016–2017 | Michigan, US [76] |
| E. tarda | 5% | Korean catfish | 24–26 °C | 2009 | Korea [179] |
| E. tarda | 5–15% | Fourfinger threadfin | ND | Taiwan [181] | |
| E. piscicida-like | 20% | White grouper | ND | 2011–2012 | Israel [124] |
| E. tarda | 30% | Brook trout | 18–19 °C | 1998 | Canada [182] |
| E. tarda | 3–10% | Turbot | 15.2–17.7 °C | 2003 | Atlantic Coast of Spain [183] |
| E. tarda | 80% | Japanese flounder | 20 °C | 1985 | Hokkaido [184] |
| E. anguillarum | 20% | Nile tilapia | 30 °C | 2019 | Chungbuk Province of Korea [87] |
| Virulence Gene | Detected in Edwardsiella Species | Mechanism |
|---|---|---|
| hemX, hemC, hemD, hemN, hemM, hemS, hmuT | E. tarda | Involved in heme biosynthesis and iron utilization, crucial for bacterial virulence and survival in host environments |
| fur | E. tarda | Ferric uptake regulator, controls iron metabolism and is linked to the expression of other virulence genes |
| basS | E. tarda | Sensor protein involved in regulation and cell signaling, possibly related to pathogen virulence |
| flhB, flhA, motA, fliG, fliR | E. tarda | Related to flagellar biosynthesis and motility, important for bacterial movement and host tissue colonization |
| tolC, tolB | E. tarda | Involved in protein translocation and drug efflux, contributing to bacterial resistance and pathogenicity |
| mltC, yjfG, imp, mrcB | E. tarda | Related to cell wall and capsule formation, crucial for structural integrity and evasion of host immune defenses |
| ompW | E. tarda | Outer membrane protein that may be involved in interactions with the host’s immune system |
| pstC, pstB, pstS | E. piscicida | Phosphate transport system components, important for bacterial metabolism and survival in the host |
| isor | E. piscicida | Iron sulfate oxidoreductase, plays a role in iron metabolism essential for pathogenicity |
| gadB | E. piscicida | Glutamate decarboxylase, may contribute to acid resistance and virulence |
| katB | E. piscicida | Catalase, involved in combating oxidative stress within the host |
| fimA | E. piscicida, E. tarda | Fimbrial protein important for adhesion to host tissues |
| qseB, qseC | E. tarda | Two-component regulatory system influencing virulence and possibly quorum sensing |
| tnaA | E. tarda | Tryptophanase, involved in indole production and potentially modulating host immune responses |
| dnaJ, htpG | E. tarda | Heat shock proteins, implicated in stress response and possibly in virulence modulation |
Disclaimer/Publisher’s Note: The statements, opinions and data contained in all publications are solely those of the individual author(s) and contributor(s) and not of MDPI and/or the editor(s). MDPI and/or the editor(s) disclaim responsibility for any injury to people or property resulting from any ideas, methods, instructions or products referred to in the content. |
© 2024 by the authors. Licensee MDPI, Basel, Switzerland. This article is an open access article distributed under the terms and conditions of the Creative Commons Attribution (CC BY) license (https://creativecommons.org/licenses/by/4.0/).
Share and Cite
Janda, J.M.; Duman, M. Expanding the Spectrum of Diseases and Disease Associations Caused by Edwardsiella tarda and Related Species. Microorganisms 2024, 12, 1031. https://doi.org/10.3390/microorganisms12051031
Janda JM, Duman M. Expanding the Spectrum of Diseases and Disease Associations Caused by Edwardsiella tarda and Related Species. Microorganisms. 2024; 12(5):1031. https://doi.org/10.3390/microorganisms12051031
Chicago/Turabian StyleJanda, J. Michael, and Muhammed Duman. 2024. "Expanding the Spectrum of Diseases and Disease Associations Caused by Edwardsiella tarda and Related Species" Microorganisms 12, no. 5: 1031. https://doi.org/10.3390/microorganisms12051031
APA StyleJanda, J. M., & Duman, M. (2024). Expanding the Spectrum of Diseases and Disease Associations Caused by Edwardsiella tarda and Related Species. Microorganisms, 12(5), 1031. https://doi.org/10.3390/microorganisms12051031






